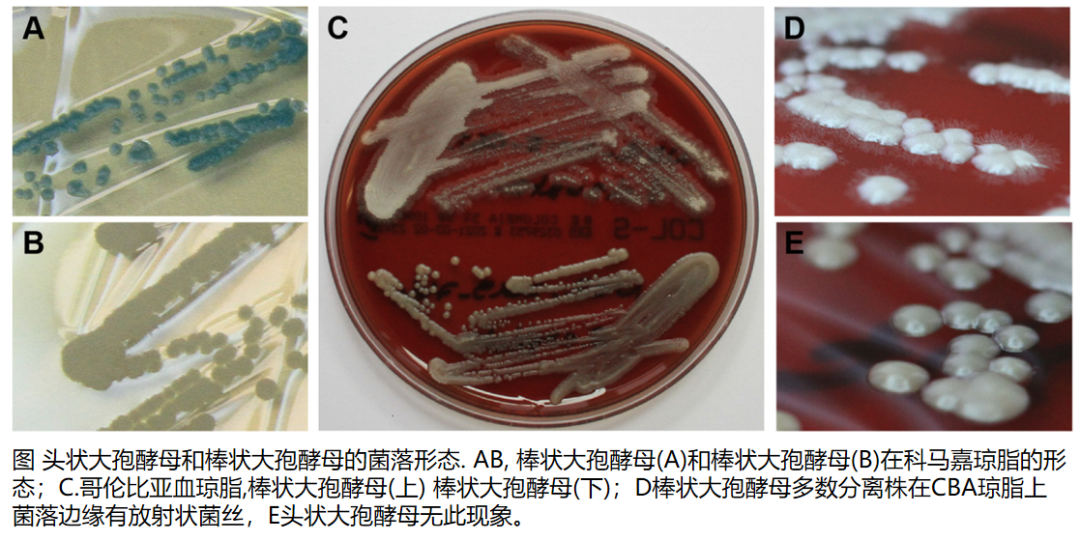
体のさまざまな領域の感染症

酵母菌またはカンジダ症は、体内に生息する真菌の一種です。通常、人の免疫システムは酵母を制御下に保ちます。しかし、特定の要因により酵母菌が増殖し、感染症を引き起こす可能性があります。
酵母感染症は体のさまざまな部分で発生する可能性があります。場合によっては、これらの感染症が長期にわたる場合や慢性的な場合もあります。
この記事では、慢性酵母菌感染症の影響を受けやすい体のさまざまな部分について概説します。また、酵母感染症の原因についても説明し、治療と予防に関するヒントも提供します。
酵母感染症は体のさまざまな領域で発生する可能性があります。以下にいくつかの例を概説します。
性器
イースト菌感染症は一般的に生殖器に影響を及ぼし、膣イースト菌感染症と陰茎イースト菌感染症が含まれます。
慢性または再発性の膣酵母感染症は、1 年に 4 回以上発生する感染症です。膣酵母感染症の症状は次のとおりです。
- 白くて無臭のおりもの
- 膣周囲のかゆみや刺激
- 性行為中または排尿時の痛みや不快感
陰茎酵母感染症の症状は次のとおりです。
- 白い陰茎分泌物
- 性器周囲の不快な臭い
- 陰茎の頭の周囲と包皮の下の発赤と刺激
- 包皮を引き戻すのが難しい
口と喉
口腔カンジダ症は、口または喉の酵母感染症です。症状には次のようなものがあります。
- 口の中の白い斑点
- 口角のひび割れ
- 味覚の喪失、または口の中の不快な味
- 口や喉の中の発赤
- 食べるときや飲み込むときの痛み
食道
場合によっては、口腔カンジダ症が食道(口と胃をつなぐ管)に広がることがあります。医師はこのタイプの酵母感染症を食道カンジダ症と呼びます。免疫力が低下している人々の間でより一般的です。
食道カンジダ症の主な症状は、痛みと嚥下困難です。
皮膚
皮膚カンジダ症は皮膚の酵母感染症です。これらの感染症は、脇の下や鼠径部など、空気の流れが少なく、暖かく湿った体の部位で発生する傾向があります。
皮膚カンジダ症の症状は次のとおりです。
- サイズが大きくなる赤い皮膚の発疹
- 皮膚のしわやひだに沿って、または身体の 2 つの部分が接する場所に発生する発疹
- 毛包の感染症。ニキビに似ていることもあります
体の他の部分
浸潤性カンジダ症は、脳、心臓、血液、および体の他の部分に影響を与える可能性がある、より重度の酵母感染症です。
免疫力が低下している人や入院生活を送っている人は、浸潤性カンジダ症を発症するリスクが高くなります。
さまざまな要因により、体のどこかに慢性的な酵母感染症が発生する可能性があります。例としては次のものが挙げられます。
基礎的な健康状態
以下の基礎的な健康状態は、慢性および再発性のイースト菌感染症のリスクを高める可能性があります。
糖尿病
免疫力の低下
免疫システムは、有害な病原体や病気から体を守ります。基礎的な健康状態によっては免疫システムが弱まり、細菌、ウイルス、真菌感染症にかかりやすくなる場合があります。例としては次のものが挙げられます。
以前の感染を排除できなかった場合
場合によっては、繰り返しのイースト菌感染症のように見えても、実際には完全には治らなかった以前のイースト菌感染症である場合があります。
抗真菌薬は酵母感染症の典型的な治療法です。たとえ症状が消えたとしても、完全な治療を受けなければなりません。
場合によっては、酵母感染症に対する最初の治療法が効かないことがあります。医師は、より長期間治療を継続するか、別の抗真菌薬に変更することを勧める場合があります。
薬
一部の薬は、体のどこかで酵母菌感染症が発生するリスクを高める可能性があります。例としては次のものが挙げられます。
- 抗生物質:抗生物質は、体内の微生物の正常なバランスを変化させます。強力な抗生物質を服用したり、長期間服用すると、酵母感染症を引き起こす可能性があります。
- コルチコステロイド:これらの薬剤は免疫系を抑制するため、重篤な酵母菌感染症を発症するリスクが高まる可能性があります。米国疾病管理予防センター (CDC) によると、吸入コルチコステロイドは口腔カンジダ症のリスクを高めます。
- ホルモン性避妊:高レベルのエストロゲンを含む避妊は、膣酵母感染症のリスクを高める可能性があります。
- TNF 阻害剤:これらの薬剤は、腫瘍壊死因子 α または「TNF-α」と呼ばれるタンパク質の放出を阻害することで炎症を軽減します。 2013年のレビューでは、TNF-αを阻害すると免疫不全を引き起こし、それによって感染症のリスクが高まる可能性があると指摘されています。
- 化学療法:化学療法治療は一時的に免疫システムを弱める可能性があり、これにより感染症のリスクも高まります。
身体障害
身体的障害によっては、皮膚酵母感染症を発症するリスクが高まる可能性があります。
酵母は、空気の流れのない暖かく湿った環境で繁殖します。身体障害のある人は、動きが制限されたり、体の特定の部分に圧力がかかり続けたりするため、皮膚への空気の流れが減少している可能性があります。
イースト菌感染症の最も一般的な治療法は抗真菌薬です。これらの薬は、次のようなさまざまな形で入手できます。
- クリーム
- 軟膏
- シャンプー
- スプレー
- 座薬
- 錠剤
人が必要とする抗真菌薬の種類は、感染の場所とその重症度によって異なります。
再発するイースト菌感染症を治療するために抗真菌薬の処方が必要になる人もいます。
ある種の再発性イースト菌感染症に対しては、医師が維持療法を推奨する場合があります。これには、イースト菌感染症の再発を防ぐために、最長 6 か月間、毎週薬を使用することが含まれます。この治療が終了すると、感染症の経験は少なくなるか、まったくなくなるはずです。
特定の酵母菌感染症を発症するリスクを下げるために実行できる手順は次のとおりです。
膣酵母感染症の予防
以下のヒントは、膣酵母感染症のリスクを軽減するのに役立ちます。
- 洗浄を避ける:洗浄により膣内の健康な細菌のレベルが低下し、膣酵母感染症が発症する可能性があります。
- 香りの付いた衛生製品を避ける:香りの付いたバブルバス、シャワージェル、生理用ナプキンは膣周囲の敏感な皮膚を刺激し、感染症のリスクを高める可能性があります。代替品として、刺激の少ない無香料の製品を使用する必要があります。
- 女性の衛生状態を良好に保つ:タンポン、パンティライナー、ナプキンを交換すると、膣酵母感染症のリスクを減らすことができます。トイレの後は前から後ろに拭くことも大切です。
- ゆったりとした通気性のある下着を着用する:生地が体の暖かく湿った部分から余分な湿気を逃がすことができるため、綿の下着を着用することをお勧めします。
皮膚酵母感染症の予防
以下のヒントは、皮膚酵母感染症のリスクを軽減するのに役立ちます。
- ゆったりとした通気性のある衣服を着用する:酵母菌は、空気の流れが制限され、暖かく湿った体の部分で繁殖します。ゆったりとした通気性のある衣服を着用すると、皮膚の表面から余分な熱と湿気が逃げます。綿と麻は良い生地の選択です。
- 湿った衣服から着替える:湿った衣服は酵母菌にとって理想的な環境です。運動が終わったらすぐに水着とトレーニングウェアを着替える必要があります。
口腔カンジダ症の予防
以下のヒントは、口腔カンジダ症のリスクを軽減するのに役立ちます。
- 良好な口腔衛生の維持:良好な口腔衛生は、口内の酵母の蓄積を防ぎます。米国歯科医師会は、1日2回歯を磨き、1日1回歯の間をフロスすることを推奨しています。
- 合わない義歯の着用を避ける:合わない義歯は、口の内側を覆う粘膜である口腔粘膜に痛みを引き起こす可能性があります。口腔粘膜の細胞が死ぬと、口腔内の酵母菌に栄養が供給されます。これにより、口腔カンジダ症が発生する可能性があります。
- 禁煙:喫煙は口腔粘膜を刺激し、酵母菌が繁殖しやすくなります。
以下のいずれかに該当する場合は、医師の診察を受ける必要があります。
- 市販(OTC)治療法に反応しない持続性または再発性のイースト菌感染症
- イースト菌感染症とは無関係に見える症状
- 免疫システムを弱める基礎疾患
医師は、他の病気を除外するために、影響を受けた体の部位を検査したい場合があります。これは、他の病気によっては酵母菌感染症に似た症状が引き起こされるためです。たとえば、膣カンジダ症の症状は細菌性膣炎の症状に似ている場合があります。後者はより重篤になる可能性があり、別の治療が必要になります。
イースト菌感染症がある場合、医師は感染症を治療するためにより強力な抗真菌薬を処方する可能性があります。
イースト菌感染症は、生殖器、皮膚、口、喉など、体のさまざまな部分で発生する可能性があります。
慢性酵母感染症は、長期間持続する感染症です。特定の薬剤や基礎的な健康状態は、特定のライフスタイル要因と同様に、慢性酵母感染症を発症するリスクを高める可能性があります。
イースト菌感染症が市販薬治療に反応しない場合は、医師の診察を受ける必要があります。医師はその部位を注意深く検査し、他の病気がないか確認します。イースト菌感染症がある場合、医師は感染症を除去するためにより強力な抗真菌薬を処方します。
慢性酵母感染症の原因と治療法・関連動画
参考文献一覧
- https://www.mouthhealthy.org/en/az-topics/o/oral-health
- https://www.womenshealth.gov/az-topics/vaginal-yeast-infections
- https://www.cdc.gov/fungal/diseases/candidiasis/thrush/index.html
- https://www.cdc.gov/fungal/infections/immune-system.html
- https://www.nhsinform.scot/illnesses-and-conditions/infections-and-poisoning/oral-thrush-in-actuals
- https://www.ncbi.nlm.nih.gov/pmc/articles/PMC3615849/